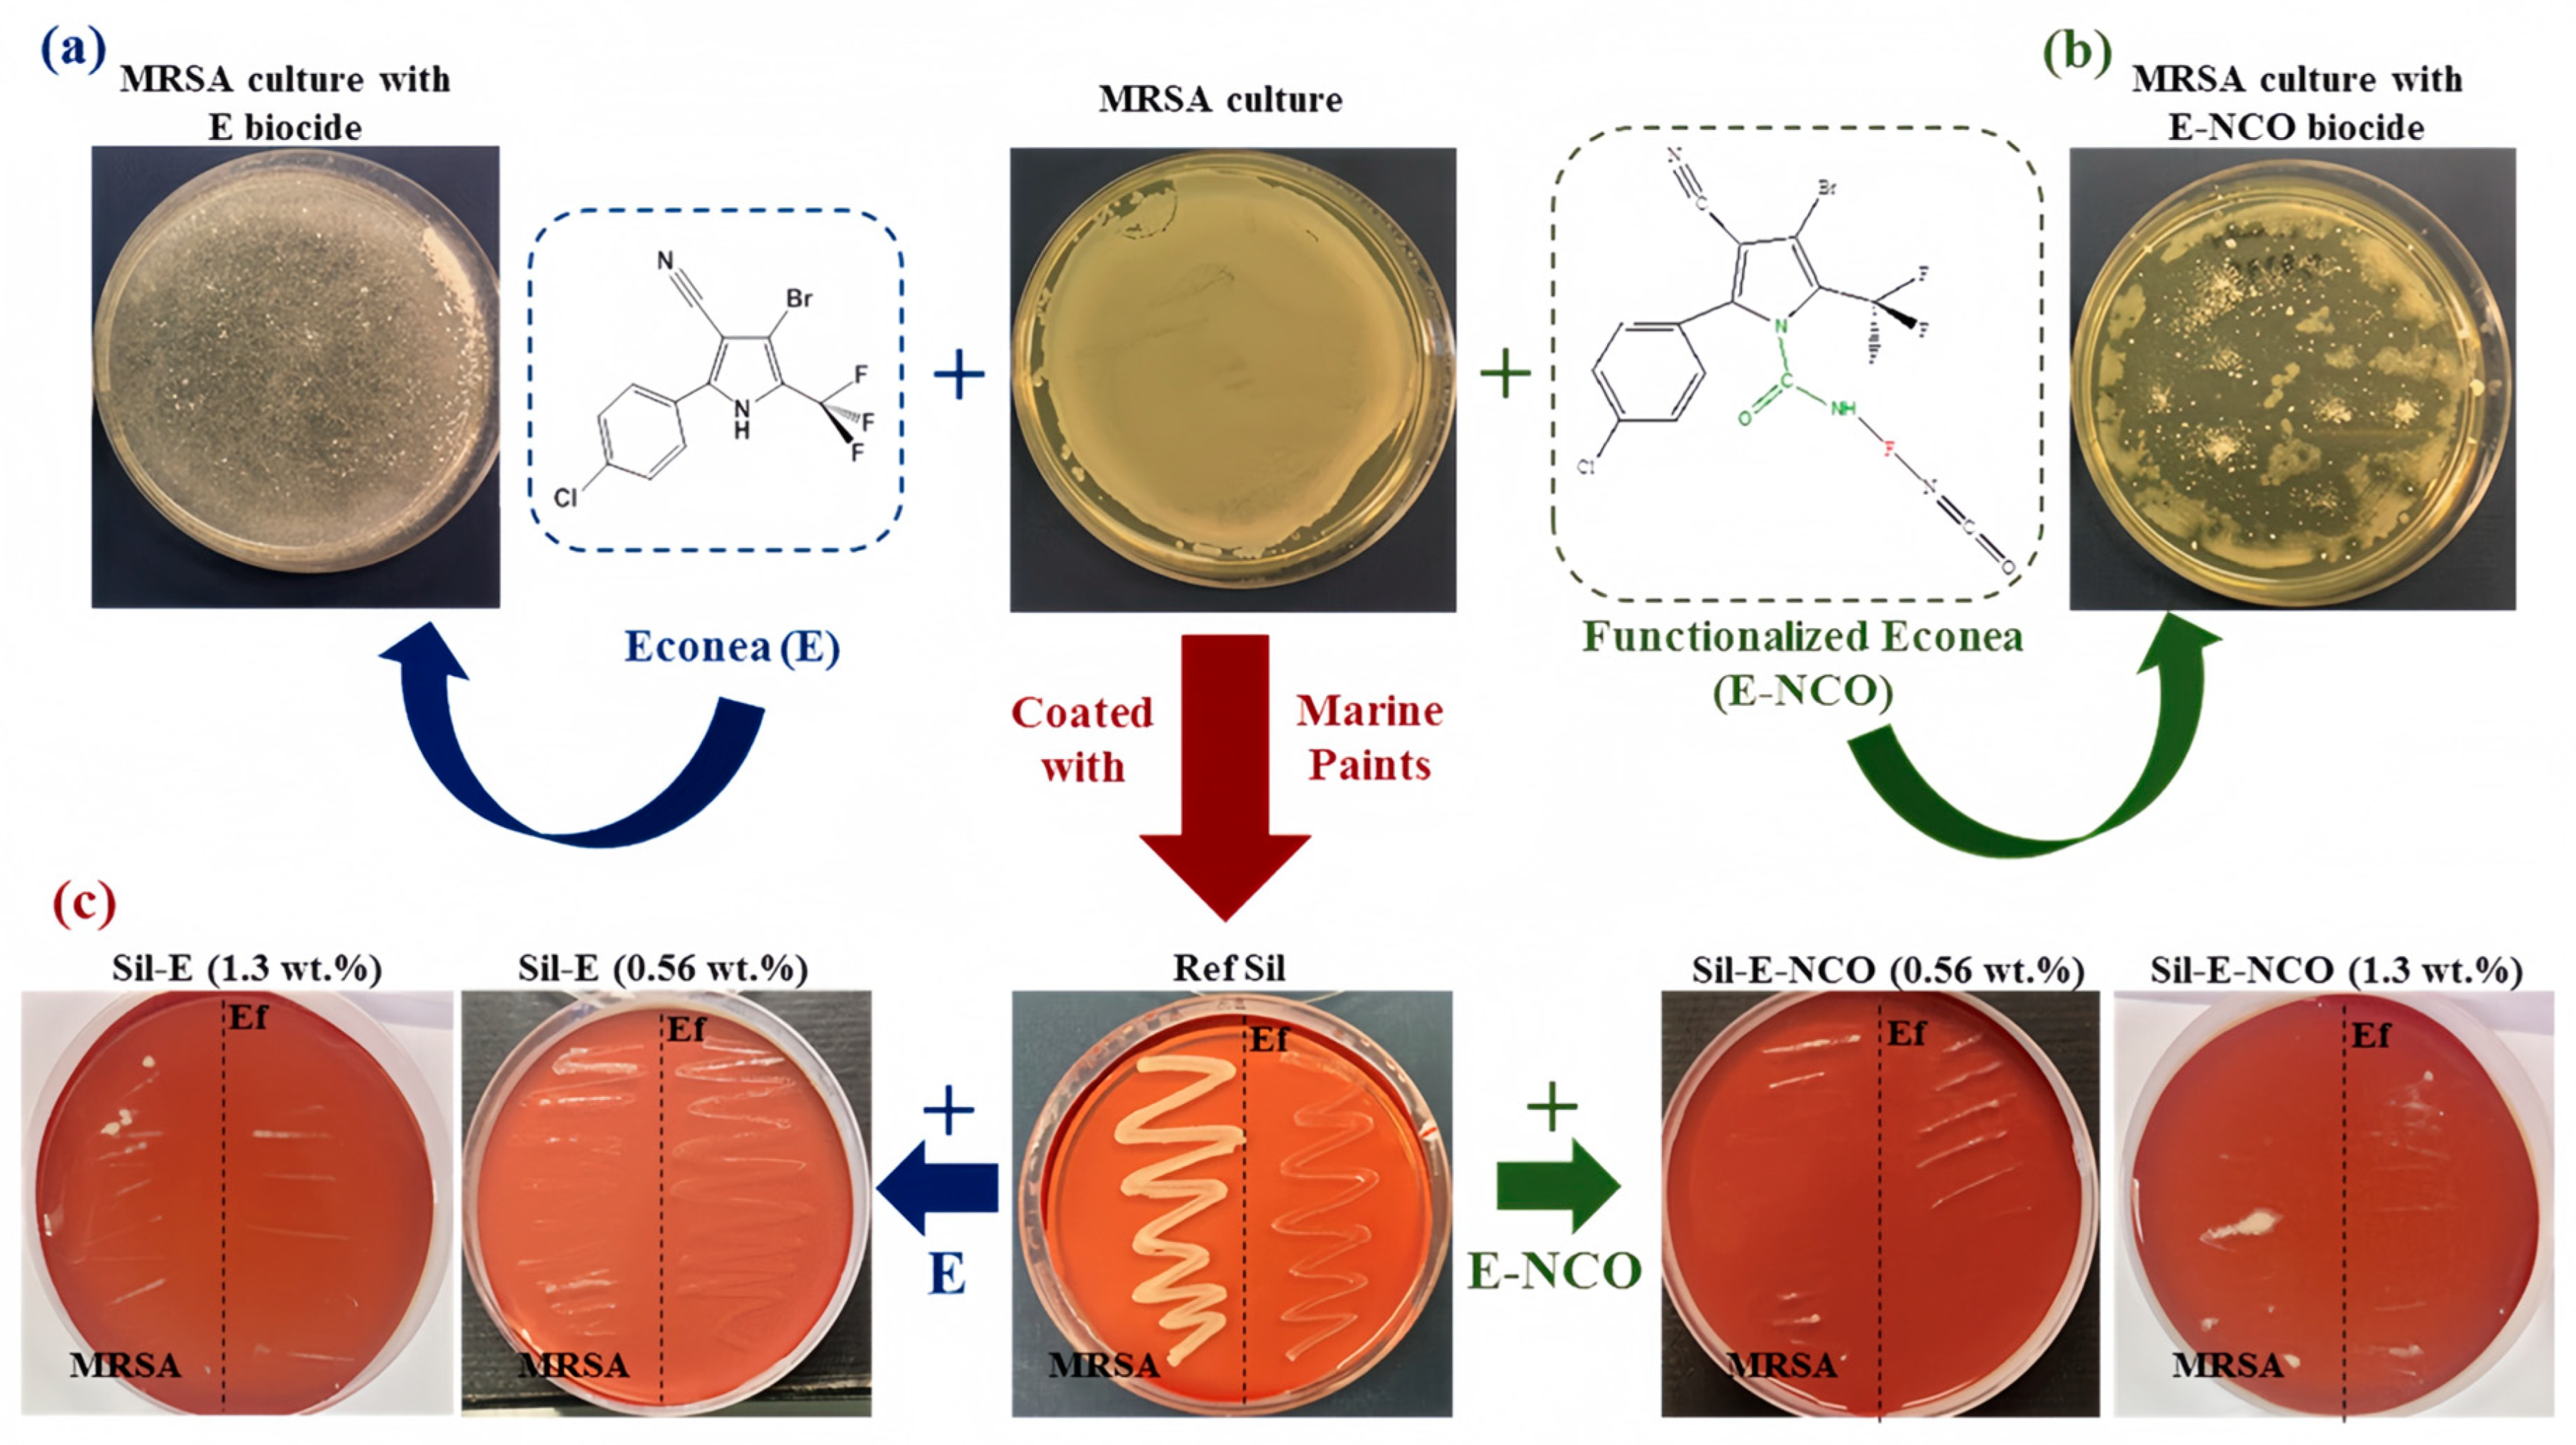
Coatings 14 01227 g004

Research Progress of Marine Anti-Fouling Coatings
Abstract
1. Introduction

2. Self-Polishing Anti-Fouling Coatings
2.1. Tin-Free Self-Polishing Anti-Fouling Coating
2.2. Additive Self-Polishing Anti-Fouling Coating
2.3. Biodegradable Self-Polishing Anti-Fouling Coatings
3. Low Surface Energy Anti-Fouling Coatings

3.1. Silicone Anti-Fouling Coatings
3.2. Organic Fluorine Low Surface Energy Anti-Fouling Coatings
4. Biomimetic Anti-Fouling Coatings
4.1. Terrestrial Plant-Based Biomimetic Anti-Fouling Coatings
4.2. Marine Bio-Based Biomimetic Anti-Fouling Coatings
5. Nano-Anti-Fouling Coating
5.1. Release-Type Nano-Anti-Fouling Coating
5.2. Nanocomposite Anti-Fouling Coatings
6. Conclusions and Prospects
Author Contributions
Funding
Conflicts of Interest
References
- Liu, Z.; Zheng, X.; Zhang, H.; Li, W.; Jiang, R.; Zhou, X. Review on formation of biofouling in the marine environment and functionalization of new marine antifouling coatings. J. Mater. Sci. 2022, 57, 18221–18242. [Google Scholar] [CrossRef]
- Selim, M.S.; El-Safty, S.A.; Shenashen, M.A.; Higazy, S.A.; Elmarakbi, A. Progress in biomimetic leverages for marine antifouling using nanocomposite coatings. J. Mater. Chem. B 2020, 8, 3701–3732. [Google Scholar] [CrossRef] [PubMed]
- Dinariyana, A.A.B. Development of Model-Driven Decision Support System to Schedule Underwater Hull Cleaning. Brodogradnja 2022, 73, 21–37. [Google Scholar] [CrossRef]
- Gu, Y.; Yu, L.; Mou, J.; Wu, D.; Xu, M.; Zhou, P.; Ren, Y. Research Strategies to Develop Environmentally Friendly Marine Antifouling Coatings. Mar. Drugs 2020, 18, 371. [Google Scholar] [CrossRef] [PubMed]
- Ni, C.; Zhao, H.; Li, L.; Huang, Y.; Wu, J.; Zhang, J.; Huang, F.; Ma, X.; Wu, L.; Cao, S. Evaluation Methods of Antifouling Coatings and their Antifouling Properties. Shanghai Coat. 2010, 48, 29–32. [Google Scholar]
- Zhang, J. Development and Application of New Marine Antifouling Coatings; South China University of Technology: Guangzhou, China, 2018. [Google Scholar]
- Gao, Q.; Zhao, J.; Wang, L.; Huang, Z.; Liu, F.; He, W.; Zhang, B.; Wu, L.; Liu, Y.; Zhang, P. Preparation of Nano-sized Cuprous Oxide and its Application in Antifouling Coatings. Shanghai Coat. 2008, 46, 30–33. [Google Scholar]
- Yang, X. Preparation of Cuprous Oxide Hollow Spheres and their Application in Marine Fouling Prevention Coatings; Hainan University: Haikou, China, 2017; pp. 5–12. [Google Scholar]
- Mao, T.; Lu, G.; Xu, C.; Yu, H.; Yu, J. Preparation and properties of polyvinylpyrrolidone-cuprous oxide microcapsule antifouling coating. Prog. Org. Coat. 2020, 141, 105317. [Google Scholar] [CrossRef]
- Farkas, A.; Degiuli, N.; Martić, I.; Vujanović, M. Greenhouse gas emissions reduction potential by using antifouling coatings in a maritime transport industry. J. Clean. Prod. 2021, 295, 126428. [Google Scholar] [CrossRef]
- Farkas, A.; Degiuli, N.; Martić, I. The impact of biofouling on the propeller performance. Ocean. Eng. 2021, 219, 108376. [Google Scholar] [CrossRef]
- Selim, M.S.; Shenashen, M.A.; El-Safty, S.A.; Higazy, S.A.; Selim, M.M.; Isago, H.; Elmarakbi, A. Recent progress in marine foul-release polymeric nanocomposite coatings. Prog. Mater. Sci. 2017, 87, 1–32. [Google Scholar] [CrossRef]
- Ali, A.; Culliton, D.; Fahad, S.; Ali, Z.; Kang, E.-T.; Xu, L. Nature-inspired anti-fouling strategies for combating marine biofouling. Prog. Org. Coat. 2024, 189, 108349. [Google Scholar] [CrossRef]
- Yebra, D.M.; Kiil, S.; Dam-Johansen, K. Antifouling technology—Past, present and future steps towards efficient and environmentally friendly antifouling coatings. Prog. Org. Coat. 2004, 50, 75–104. [Google Scholar] [CrossRef]
- Rajagopalan, N.; Kiil, S. Self-sustaining antifouling coating for underwater solar cells. Prog. Org. Coat. 2024, 196, 108754. [Google Scholar] [CrossRef]
- Sun, B.-K.; Fan, H.-S.; Pan, X.-L.; Lu, A.-D.; Hu, J.-K. No Copper Based on Acrylic Resin Polishing Antifouling Paint Development. J. Surf. Technol. 2022, 51, 280–286. [Google Scholar] [CrossRef]
- Zhou, P.; Huang, J.; He, C. Synthesis of bromopyrrolonitrile derivatives and preliminary studies on their biological activities. J. Pestic. Sci. 2022, 24, 1367–1376. [Google Scholar]
- Dong, M.; Liu, L.; Wang, D.; Li, M.; Yang, J.; Chen, J. Synthesis and Properties of Self-Polishing Antifouling Coatings Based on BIT-Acrylate Resins. Coatings 2022, 12, 891. [Google Scholar] [CrossRef]
- Lagerstrom, M.; Ytreberg, E.; Wiklund, A.E.; Granhag, L. Antifouling paints leach copper in excess - study of metal release rates and efficacy along a salinity gradient. Water Res. 2020, 186, 116383. [Google Scholar] [CrossRef]
- Wang, S.; Qiu, B.; Shi, J.; Wang, M. Quaternary ammonium antimicrobial agents and their application in antifouling coatings: A review. J. Coat. Technol. Res. 2023, 21, 87–103. [Google Scholar] [CrossRef]
- Hu, K.; Li, M.; You, C.; Zhang, Y.; Xu, Z.; Xu, Y.; Fan, L.; Yi, Y.; Chu, Y. Novel indole-based self-polishing environmentally friendly acrylic antifouling coatings. Prog. Org. Coat. 2024, 190, 108384. [Google Scholar] [CrossRef]
- Zuena, M.; Ruggiero, L.; Della Ventura, G.; Bemporad, E.; Ricci, M.A.; Sodo, A. Effectiveness and Compatibility of Nanoparticle Based Multifunctional Coatings on Natural and Man-Made Stones. Coatings 2021, 11, 480. [Google Scholar] [CrossRef]
- Pérez, M.; Fernández, L.R.; Zambrano, E.E.; García, M.; Uriburu, M.L.; Sánchez, M.; Blustein, G.; Palermo, J.A. Use of Weed Extracts as Antifouling Additives for Marine Paints: Two Case Studies. Rev. Bras. Farmacogn. 2021, 31, 420–428. [Google Scholar] [CrossRef]
- Bo, Z. Preparation and Research of Pure Waterborne Polyurethane Nano Emulsion and Its Antibacterial and Superhydrophobic Coating; Shanghai University of Applied Science: Shanghai, China, 2019; pp. 19–33. [Google Scholar]
- An, X.; Dong, W.; Yang, C.; Li, X. Synthesis of Novel Capillary Derivatives and their Antifouling Properties. Coat. Ind. 2022, 52, 44–50. [Google Scholar]
- Ferreira, O.; Rijo, P.; Gomes, J.F.; Santos, R.; Monteiro, S.; Vilas-Boas, C.; Correia-da-Silva, M.; Almada, S.; Alves, L.G.; Bordado, J.C.; et al. Biofouling Inhibition with Grafted Econea Biocide: Toward a Nonreleasing Eco-Friendly Multiresistant Antifouling Coating. ACS Sustain. Chem. Eng. 2019, 8, 12–17. [Google Scholar] [CrossRef]
- Chen, G.; Chen, S.; Zhuang, Y. Research progress of environmental friendly Marine coatings. China Coat. 2020, 35, 7–10. [Google Scholar] [CrossRef]
- Li-guo, X. Synthesis of Biodegradable Polyurethane and Its Marine Antipollution Performance; South China University of Technology: Guangzhou, China, 2012. [Google Scholar]
- Sha, J.; Yu, J.; Chen, R.; Liu, Q.; Liu, J.; Zhu, J.; Liu, P.; Li, R.; Wang, J. Eco-friendly self-polishing antifouling coating via eugenol ester hydrolysis. Prog. Org. Coat. 2022, 172, 107077. [Google Scholar] [CrossRef]
- Dai, Z.; Cao, M.; Li, S.; Yao, J.; Wu, B.; Wang, Y.; Wang, H.; Dong, J.; Yi, J. A novel marine antifouling coating based on a self-polishing zinc-polyurethane copolymer. J. Coat. Technol. Res. 2021, 18, 1333–1343. [Google Scholar] [CrossRef]
- Król, B.; Król, P.; Byczyński, Ł.; Szałański, P. Methods of increasing hydrophobicity of polyurethane materials: Important applications of coatings with low surface free energy. Colloid. Polym. Sci. 2017, 295, 2309–2321. [Google Scholar] [CrossRef]
- Lejars, M.; Margaillan, A.; Bressy, C. Fouling release coatings: A nontoxic alternative to biocidal antifouling coatings. Chem. Rev. 2012, 112, 4347–4390. [Google Scholar] [CrossRef]
- Baier, R.E.; Meyer, A.E. Surface analysis of fouling—Resistant marine coatings. Biofouling 1992, 6, 165–180. [Google Scholar] [CrossRef]
- Liu, D.; Zhao, J. Marine heavy duty anticorrosive coatings and coating system status and development trend. Coat. Technol. 2014, 29, 19–22. [Google Scholar] [CrossRef]
- Lei, H.; Xiong, M.; Xiao, J.; Zheng, L.; Zhuang, Q. Fluorine-free coating with low surface energy and anti-biofouling properties. Prog. Org. Coat. 2018, 124, 158–164. [Google Scholar] [CrossRef]
- Xu, L.M. Synthesis of Acrylic Resin Modified by Organic Fluorine and Study on Its Coating; Dalian Jiaotong University: Dalian, China, 2010; pp. 5–45. [Google Scholar]
- Hu, P.; Xie, Q.; Ma, C.; Zhang, G. Silicone-Based Fouling-Release Coatings for Marine Antifouling. Langmuir 2020, 36, 2170–2183. [Google Scholar] [CrossRef] [PubMed]
- An, X.; Chen, J.; Li, Q.; Tang, J.; Li, Z.; Liu, L.; Yang, H.; Wei, C. Development of a mechanically robust silicon-based cross-linking polymer for the sustainable marine antifouling coatings. Sustain. Mater. Technol. 2024, 41, e01015. [Google Scholar] [CrossRef]
- Chen, Q.a.; Zhang, Z.; Hao, S.; Qi, Y. Effects of incorporated silicone oils on the antifouling and drag reduction of Fe2O3/PDMS coatings. Mater. Today Commun. 2023, 37, 107409. [Google Scholar] [CrossRef]
- Yang, Q.; Zhang, Z.; Qi, Y.; Zhang, H. Influence of Phenylmethylsilicone Oil on Anti-Fouling and Drag-Reduction Performance of Silicone Composite Coatings. Coatings 2020, 10, 1239. [Google Scholar] [CrossRef]
- Yang, Q.; Zhang, Z.; Qi, Y.; Zhang, H. The Antifouling and Drag-Reduction Performance of Alumina Reinforced Polydimethylsiloxane Coatings Containing Phenylmethylsilicone Oil. Polymers 2021, 13, 3067. [Google Scholar] [CrossRef]
- Gao, Z.; Jiang, D.; Zhang, Q.; Li, X. Research Progress of Marine Antifouling Coatings with Low Surface Energy Containing Fluorine. Electroplat. Finish. 2017, 36, 273–279. [Google Scholar] [CrossRef]
- Zhao, K.; Zhang, W.; Sun, B.; Chen, K.; Song, J. Research Progress of Fluorocarbon Coatings. Zhejiang Chem. Ind. 2023, 54, 4–8. [Google Scholar] [CrossRef]
- Zhang, K. Study on Process, Wear Resistance Mechanism and Life Prediction of Carbon Fiber Filling Polytetrafluoroethylene; Shanghai University of Engineering Science: Shanghai, China, 2021. [Google Scholar]
- Zhang, Z.; Chen, R.; Yu, J.; Sun, G.; Liu, Q.; Liu, J.; Zhu, J.; Liu, P.; Wang, J. Fluorocarbon-based self-layering interpenetrating polymer-network coatings with anti-fouling and anti-icing properties. Chem. Eng. J. 2023, 474, 145540. [Google Scholar] [CrossRef]
- Yang, Z.; Bai, Y.; Wei, B.; Cui, Y.; Wang, R.; Zhang, W.; Li, Y.; Meng, L.; Wang, Y. Facile synthesis of UV-curable fluorosilicone polymers and coatings with good corrosive resistance on account of the reaction of disulfide bonds with vinyl groups. Prog. Org. Coat. 2024, 188, 108236. [Google Scholar] [CrossRef]
- Cheng, Y.-H.; Wu, C.-T.; Hu, L.-H. Dual functional low surface energy coating of anti-corrosion / fouling via crosslinking polysilazane preceramic precursor incorporated with fluorine. Prog. Org. Coat. 2023, 177, 107409. [Google Scholar] [CrossRef]
- Song, F.; Zhang, L.; Chen, R.; Liu, Q.; Liu, J.; Yu, J.; Liu, P.; Duan, J.; Wang, J. Bioinspired Durable Antibacterial and Antifouling Coatings Based on Borneol Fluorinated Polymers: Demonstrating Direct Evidence of Antiadhesion. ACS Appl. Mater. Interfaces 2021, 13, 33417–33426. [Google Scholar] [CrossRef] [PubMed]
- Park, J.M.; Lee, Y.H.; Park, H.; Kim, H.D. Preparation and properties of UV-curable fluorinated polyurethane acrylates. J. Appl. Polym. Sci. 2014, 131, 40603. [Google Scholar] [CrossRef]
- Brzozowska, A.M.; Maassen, S.; Goh Zhi Rong, R.; Benke, P.I.; Lim, C.S.; Marzinelli, E.M.; Jańczewski, D.; Teo, S.L.; Vancso, G.J. Effect of Variations in Micro-patterns and SurfaceModulus on Marine Fouling of Engineering Polymers. ACS Appl. Mater. Terfaces 2017, 9, 17508. [Google Scholar] [CrossRef] [PubMed]
- Ramalingam, B.; Das, S.K. Biomimetic strategy for fabrication of bifunctional graphene oxide-biomaterial aerogel as highly porous antifouling material for oil/water separation. Chem. Eng. J. 2023, 475, 145906. [Google Scholar] [CrossRef]
- Ware, C.S.; Smith-Palmer, T.; Peppou-Chapman, S.; Scarratt, L.R.J.; Humphries, E.M.; Balzer, D.; Neto, C. Marine Antifouling Behavior of Lubricant-Infused Nanowrinkled Polymeric Surfaces. ACS Appl. Mater. Interfaces 2018, 10, 4173–4182. [Google Scholar] [CrossRef]
- Jin, E. Bionic Anti-Fouling Functional Surface Design based on Static Anti-Fouling Strategy of Garland Fleshy Soft Coral; Jilin University: Changchun, China, 2022. [Google Scholar]
- Zhou, K. Bionic Salvinia Natans Ping High Adhesion Super Hydrophobic Preparation and Study on the Surface of the Water Meter; Dalian Maritime University: Dalian, China, 2020. [Google Scholar]
- Zhang, P.; Lin, L.; Zang, D.; Guo, X.; Liu, M. Designing Bioinspired Anti-Biofouling Surfaces based on a Superwettability Strategy. Small 2017, 13, 1503334. [Google Scholar] [CrossRef]
- Darmanin, T.; Guittard, F. Superhydrophobic and superoleophobic properties in nature. Mater. Today 2015, 18, 273–285. [Google Scholar] [CrossRef]
- Jiang, R.; Hao, L.; Song, L.; Tian, L.; Fan, Y.; Zhao, J.; Liu, C.; Ming, W.; Ren, L. Lotus-leaf-inspired hierarchical structured surface with non-fouling and mechanical bactericidal performances. Chem. Eng. J. 2020, 398, 125609. [Google Scholar] [CrossRef]
- Magin, C.M.; Cooper, S.P.; Brennan, A.B. Non-toxic antifouling strategies. Mater. Today 2010, 13, 36. [Google Scholar] [CrossRef]
- Nagamine, H.; Yamahata, K.; Hagiwara, Y.; Matsubara, R. Turbulence modification by compliant skin and strata-corneas desquamation of a swimming dolphin. J. Turbul. 2004, 5, 18. [Google Scholar] [CrossRef]
- Mo, Y.; Xue, P.; Yang, Q.; Liu, H.; Zhao, X.; Wang, J.; Jin, M.; Qi, Y. Composite Slow-Release Fouling Release Coating Inspired by Synergistic Anti-Fouling Effect of Scaly Fish. Polymers 2021, 13, 2602. [Google Scholar] [CrossRef] [PubMed]
- Lin, Y.-T.; Ting, Y.-S.; Chen, B.-Y.; Cheng, Y.-W.; Liu, T.-Y. Bionic shark skin replica and zwitterionic polymer brushes functionalized PDMS membrane for anti-fouling and wound dressing applications. Surf. Coat. Technol. 2020, 391, 125663. [Google Scholar] [CrossRef]
- Dundar Arisoy, F.; Kolewe, K.W.; Homyak, B.; Kurtz, I.S.; Schiffman, J.D.; Watkins, J.J. Bioinspired Photocatalytic Shark-Skin Surfaces with Antibacterial and Antifouling Activity via Nanoimprint Lithography. ACS Appl. Mater. Interfaces 2018, 10, 20055–20063. [Google Scholar] [CrossRef] [PubMed]
- Qin, Y.; Wang, S.; Fan, Y.; Wang, L.; Zhang, C.; Zhao, J.; Ren, L. Osthole-infused polyurethane flexible coatings for enhanced underwater drag reduction and robust anti-biofouling. Prog. Org. Coat. 2024, 188. [Google Scholar] [CrossRef]
- Pourhashem, S.; Seif, A.; Saba, F.; Nezhad, E.G.; Ji, X.; Zhou, Z.; Zhai, X.; Mirzaee, M.; Duan, J.; Rashidi, A.; et al. Antifouling nanocomposite polymer coatings for marine applications: A review on experiments, mechanisms, and theoretical studies. J. Mater. Sci. Technol. 2022, 118, 73–113. [Google Scholar] [CrossRef]
- Mahmoudpour, M.; Jouyban, A.; Soleymani, J.; Rahimi, M. Rational design of smart nano-platforms based on antifouling-nanomaterials toward multifunctional bioanalysis. Adv. Colloid. Interface Sci. 2022, 302, 102637. [Google Scholar] [CrossRef]
- Hou, J.; Zhao, H.; Zhang, Z.; Yu, L.; Yan, X. The antifouling tris-(8-hydroxyquinoline) aluminum: Titanium dioxide coatings under visible light. Surf. Coat. Technol. 2023, 468, 129743. [Google Scholar] [CrossRef]
- Sayed, F.A.; Eissa, N.G.; Shen, Y.; Hunstad, D.A.; Wooley, K.L.; Elsabahy, M. Morphologic design of nanostructures for enhanced antimicrobial activity. J. Nanobiotechnol. 2022, 20, 536. [Google Scholar] [CrossRef]
- Haider, M.S.; Shao, G.N.; Imran, S.M.; Park, S.S.; Abbas, N.; Tahir, M.S.; Hussain, M.; Bae, W.; Kim, H.T. Aminated polyethersulfone-silver nanoparticles (AgNPs-APES) composite membranes with controlled silver ion release for antibacterial and water treatment applications. Mater. Sci. Eng. C Mater. Biol. Appl. 2016, 62, 732–745. [Google Scholar] [CrossRef]
- Li, L. Study on Preparation and Corrosion Resistance of Nano-Composite Coatings; Tianjin University: Tianjin, China, 2005. [Google Scholar]
- Islam, M.J.; Khatun, N.; Bhuiyan, R.H.; Sultana, S.; Ali Shaikh, M.A.; Amin Bitu, M.N.; Chowdhury, F.; Islam, S. Psidium guajava leaf extract mediated green synthesis of silver nanoparticles and its application in antibacterial coatings. RSC Adv. 2023, 13, 19164–19172. [Google Scholar] [CrossRef] [PubMed]
- Li, X.Y.; Jiang, J.P.; Gu, X.X.; Fu, B. The Preparation of Nanometer Silver Antibacterial Antifouling Paint. Ind. Jiangxi Prov. 2022, 38, 13–15. [Google Scholar] [CrossRef]
- Cui, J.-X.; Zhang, H.-P.; Zhang, H.; Shao, Y.Y.; Zhu, J.X. Preparation and Properties of a Novel Long-Acting Nano-Silver Antibacterial Powder Coating. Coat. Prot. 2019, 41, 22–26. [Google Scholar]
- Liu, Y.F.; Li, M.; Zhao, X.; Zhang, R.; Zhang, Y.X.; Xing, Y.L. Preparation of Silver Nanoparticles and their Application in Antibacterial Coatings. New Chem. Mater. 2019, 47, 37–41. [Google Scholar]
- Lischer, S.; Korner, E.; Balazs, D.J.; Shen, D.; Wick, P.; Grieder, K.; Haas, D.; Heuberger, M.; Hegemann, D. Antibacterial burst-release from minimal Ag-containing plasma polymer coatings. J. R. Soc. Interface 2011, 8, 1019–1030. [Google Scholar] [CrossRef]
- Song, L.; Hu, J.; Huang, X.; Zhong, L.; Pei, Y.; Wu, L.; Zhang, X. Superhydrophobic Self-Healing Coatings Comprised of Hemispherical Particles Arrays Decorated by Fluorocarbon-Coated Nanoscale Fe2O3 Rods and SiO2 Particles. ACS Appl. Nano Mater. 2020, 3, 10342–10348. [Google Scholar] [CrossRef]
- Shi, X.; Wei, H.; Zhou, W.; Soto Rodriguez, P.E.D.; Lin, C.; Wang, L.; Zhang, Z. Advanced strategies for marine antifouling based on nanomaterial-enhanced functional PDMS coatings. Nano Mater. Sci. 2024, 6, 375–395. [Google Scholar] [CrossRef]
- Mancillas-Salas, S.; Ledon-Smith, J.A.; Perez-Alvarez, M.; Cadenas-Pliego, G.; Mata-Padilla, J.M.; Andrade-Guel, M.; Esparza-Gonzalez, S.C.; Vargas-Gutierrez, G.; Sierra-Gomez, U.A.; Saucedo-Salazar, E.M. Nanostructured Copper Selenide Coatings for Antifouling Applications. Polymers 2024, 16, 489. [Google Scholar] [CrossRef]
- Jiang, Y.; Wang, C.; Liu, Z.; Zhang, M.; Zhang, J.; Liu, Q.; Zhang, D.; Liu, Y. Anti-corrosion and anti-fouling superhydrophobic silicone coating with continuous micro/nano structure. Prog. Org. Coat. 2024, 188, 108230. [Google Scholar] [CrossRef]
- Chang, X.T.; Li, J.Y.; Chen, X.Q.; Wang, D.S.; Jiang, Y.C.; Sun, S.B. Preparation of magnetic Fe-MOF-doped nanosilver-based environmentally friendly composite antifouling agent and its performance. Surf. Technol. 2022, 51, 48–58. [Google Scholar] [CrossRef]
- Garralaga, M.P.; Lomba, L.; Zuriaga, E.; Santander, S.; Giner, B. Key Properties for the Toxicity Classification of Chemicals: A Comparison of the REACH Regulation and Scientific Studies Trends. Appl. Sci. 2022, 12, 11710. [Google Scholar] [CrossRef]
- McNeil, E.M. Antifouling: Regulation of biocides in the UK before and after Brexit. Mar. Policy 2018, 92, 58–60. [Google Scholar] [CrossRef]
- Schwirn, K.; Voelker, D.; Galert, W.; Quik, J.; Tietjen, L. Environmental Risk Assessment of Nanomaterials in the Light of New Obligations Under the REACH Regulation: Which Challenges Remain and How to Approach Them? Integr. Environ. Assess. Manag. 2020, 16, 706–717. [Google Scholar] [CrossRef] [PubMed]
- Nwuzor, I.C.; Idumah, C.I.; Nwanonenyi, S.C.; Ezeani, O.E. Emerging trends in self-polishing anti-fouling coatings for marine environment. Saf. Extrem. Environ. 2021, 3, 9–25. [Google Scholar] [CrossRef]

| Types of Anti-Fouling Coatings | Research Direction | Advantages | Disadvantages |
|---|---|---|---|
| Silicone low surface energy anti-fouling coatings | Addition of small molecule silicone oil | Enhanced mechanical properties and anti-fouling properties of the coating, environmentally friendly, non-toxic | (1) The need to balance the mechanical properties of coatings with anti-fouling properties. (2) Lack of broad spectrum. (3) Poor anti-fouling performance at low speeds or under stationary conditions. |
| Improvement of the coating matrix | Relatively small modulus of elasticity, non-toxic, environmentally friendly | ||
| Organic fluorine low surface energy anti-fouling coatings | Fluorinated acrylic resins | Low surface energy, low friction, reduced fouling bio-adhesion | High processing costs and complex preparation |
| Perfluoropolyether polymers | Better suppleness and lower coefficient of friction |
| Coating Category | Anti-Fouling Mechanisms | Advantages | Disadvantages |
|---|---|---|---|
| Release-type Nano-Anti-Fouling Coating | The release of nanoparticles and ions kills bacterial cells and inhibits the growth of soiled materials | Enables controlled release and better anti-fouling at lower concentrations | (1) The slow release of anti-fouling agents leads to the gradual loss of anti-fouling activity. (2) The anti-fouling mechanism of some nano-anti-fouling agents is still unclear. |
| Nanocomposite anti-fouling coatings | Multiple anti-fouling strategies work synergistically | (1) Improve the adhesion, hardness, finish, and aging resistance of the coating. (2) The formed micro- and nanocomposite structures can improve the hydrophobicity of the samples and obtain the self-cleaning effect. | High processing costs and complex preparation |
Disclaimer/Publisher’s Note: The statements, opinions and data contained in all publications are solely those of the individual author(s) and contributor(s) and not of MDPI and/or the editor(s). MDPI and/or the editor(s) disclaim responsibility for any injury to people or property resulting from any ideas, methods, instructions or products referred to in the content. |
© 2024 by the authors. Licensee MDPI, Basel, Switzerland. This article is an open access article distributed under the terms and conditions of the Creative Commons Attribution (CC BY) license (https://creativecommons.org/licenses/by/4.0/).
Share and Cite
Wu, S.; Wu, S.; Xing, S.; Wang, T.; Hou, J.; Zhao, Y.; Li, W. Research Progress of Marine Anti-Fouling Coatings. Coatings 2024, 14, 1227. https://doi.org/10.3390/coatings14091227
Wu S, Wu S, Xing S, Wang T, Hou J, Zhao Y, Li W. Research Progress of Marine Anti-Fouling Coatings. Coatings. 2024; 14(9):1227. https://doi.org/10.3390/coatings14091227
Chicago/Turabian StyleWu, Shaoqian, Shuo Wu, Shilong Xing, Tianshu Wang, Jiabin Hou, Yuantao Zhao, and Wenge Li. 2024. "Research Progress of Marine Anti-Fouling Coatings" Coatings 14, no. 9: 1227. https://doi.org/10.3390/coatings14091227
APA StyleWu, S., Wu, S., Xing, S., Wang, T., Hou, J., Zhao, Y., & Li, W. (2024). Research Progress of Marine Anti-Fouling Coatings. Coatings, 14(9), 1227. https://doi.org/10.3390/coatings14091227

